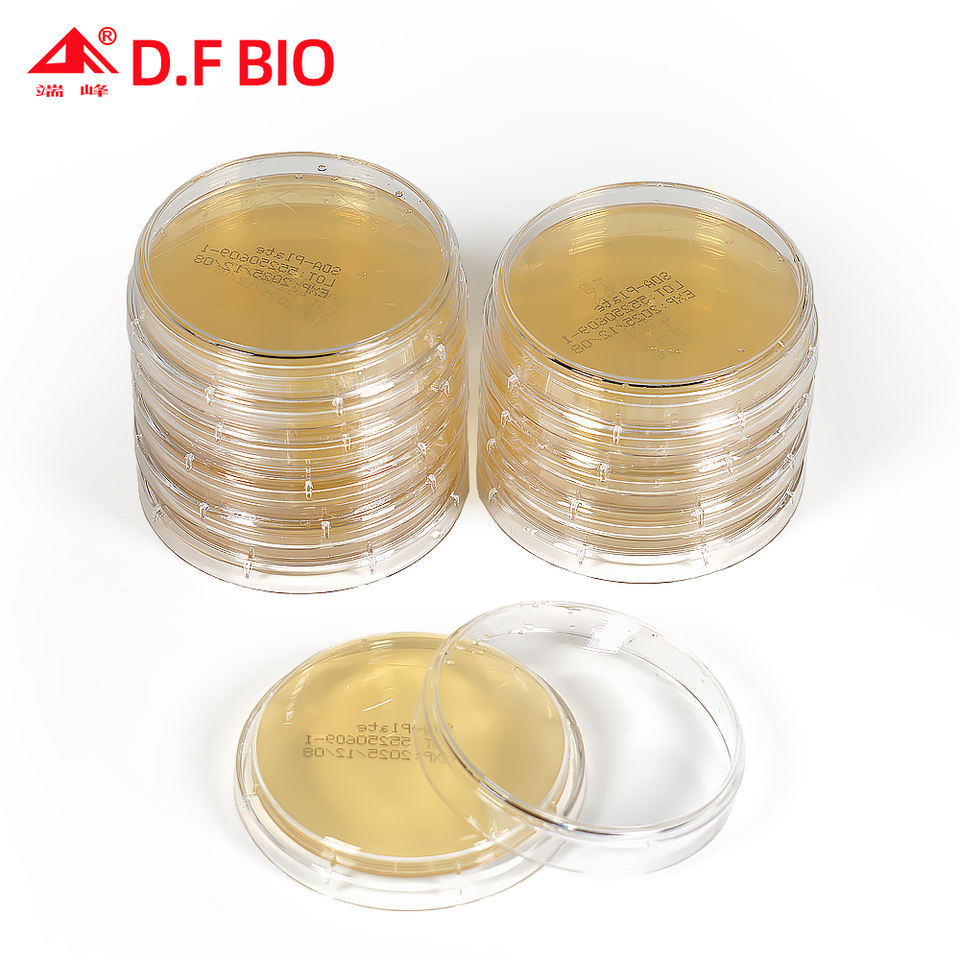

Placa de Contacto Duanfeng R2A de 55 mm | Placa de Contacto de Agar 2A de Reasoner para Pruebas de Microbiología de Agua y Alimentos, Paquete de 10
Sin reseñas

Atributos
NingunoGarantía
OEMSoporte personalizado
Jiangsu, ChinaLugar del origen
duanfengMarca
25 mlCapacidad
Según la farmacopea para la preparaciónMaterial
Tamaño:10 por paquete
Nombre del producto:Plato
Uso:Investigación Científica
Palabra clave:Ambiental

Jiangsu Duanfeng Biotechnology Co., Ltd.
CN1 años en Alibaba.com
Tiempo de respuesta ≤ 1hTasa de entregas a tiempo ≥ 100%
Características clave
Garantía
Ninguno
Soporte personalizado
OEM
Lugar del origen
Jiangsu, China
Marca
duanfeng
Capacidad
25 ml(0.85fl.oz)
Material
Según la farmacopea para la preparación
Tamaño
10 por paquete
Nombre del producto
Plato
Uso
Investigación Científica
Palabra clave
Ambiental
Empaque y entrega
Unidades de venta
Artículo individual
Tamaño del paquete
11X11X20 cm
Peso bruto
0.500 kg
Tiempo de entrega
GRATIS envío, hasta un máximo de EUR 20

15 - 29 bolsos
EUR 657
30 - 99 bolsos
EUR 613
>= 100 bolsos
EUR 569
*Los impuestos y los cargos por importación se calcularán al finalizar la compra
Cantidad
Envío
Subtotal del artículo
EUR 0.00
Total del envío
Por definir
Total antes de impuestos
EUR 0.00
4 pagos sin intereses con
Protección de pedidos de Alibaba.com
Pagos seguros
Todos tus pagos realizados en Alibaba.com están protegidos por cifrado SSL y protocolos de protección de datos PCI DSS
Entrega vía
Espera que tu pedido sea entregado antes de las fechas programadas o recibe una compensación del 10% por retraso
Garantía de devolución de dinero
Solicita un reembolso si tu pedido no se envía, no llega o hay defectos en el producto














